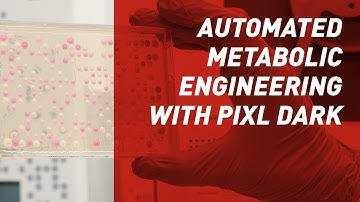
Metabolic engineering automated with PIXL Dark- Singer Instruments

⬇ DOWNLOAD NOW
Kalau muncul iklan pop-up, tutup lalu klik tombol kembali
Download lagu Walkaway Automated Colony Picking: PIXL Dark - Singer Instruments. secara gratis hanya untuk keperluan promosi. Dukung artis favorit kamu dengan membeli musik original di iTunes atau platform resmi lainnya.
Metabolic engineering automated with PIXL Dark- Singer Instruments
Metabolic engineering automated with PIXL Dark- Singer Instruments
 A Very Unusual Town - AI Music Video
A Very Unusual Town - AI Music Video
 Into The Ether – The Road That Waits for Me (Official Music Video) | Grunge Rock / Alt-Metal
Into The Ether – The Road That Waits for Me (Official Music Video) | Grunge Rock / Alt-Metal
 Honest - Kyndal Inskeep & Song House (Official Music Video)
Honest - Kyndal Inskeep & Song House (Official Music Video)
 Parachute - Kyndal Inskeep & Song House (Official Music Video)
Parachute - Kyndal Inskeep & Song House (Official Music Video)
 YESTERDAZE | Official Music Video
YESTERDAZE | Official Music Video
 The Songs are Gone/Alloya/Official Music Video
The Songs are Gone/Alloya/Official Music Video
 HUGELY POPULAR MUSIC VIDEO REMOVED…
HUGELY POPULAR MUSIC VIDEO REMOVED…